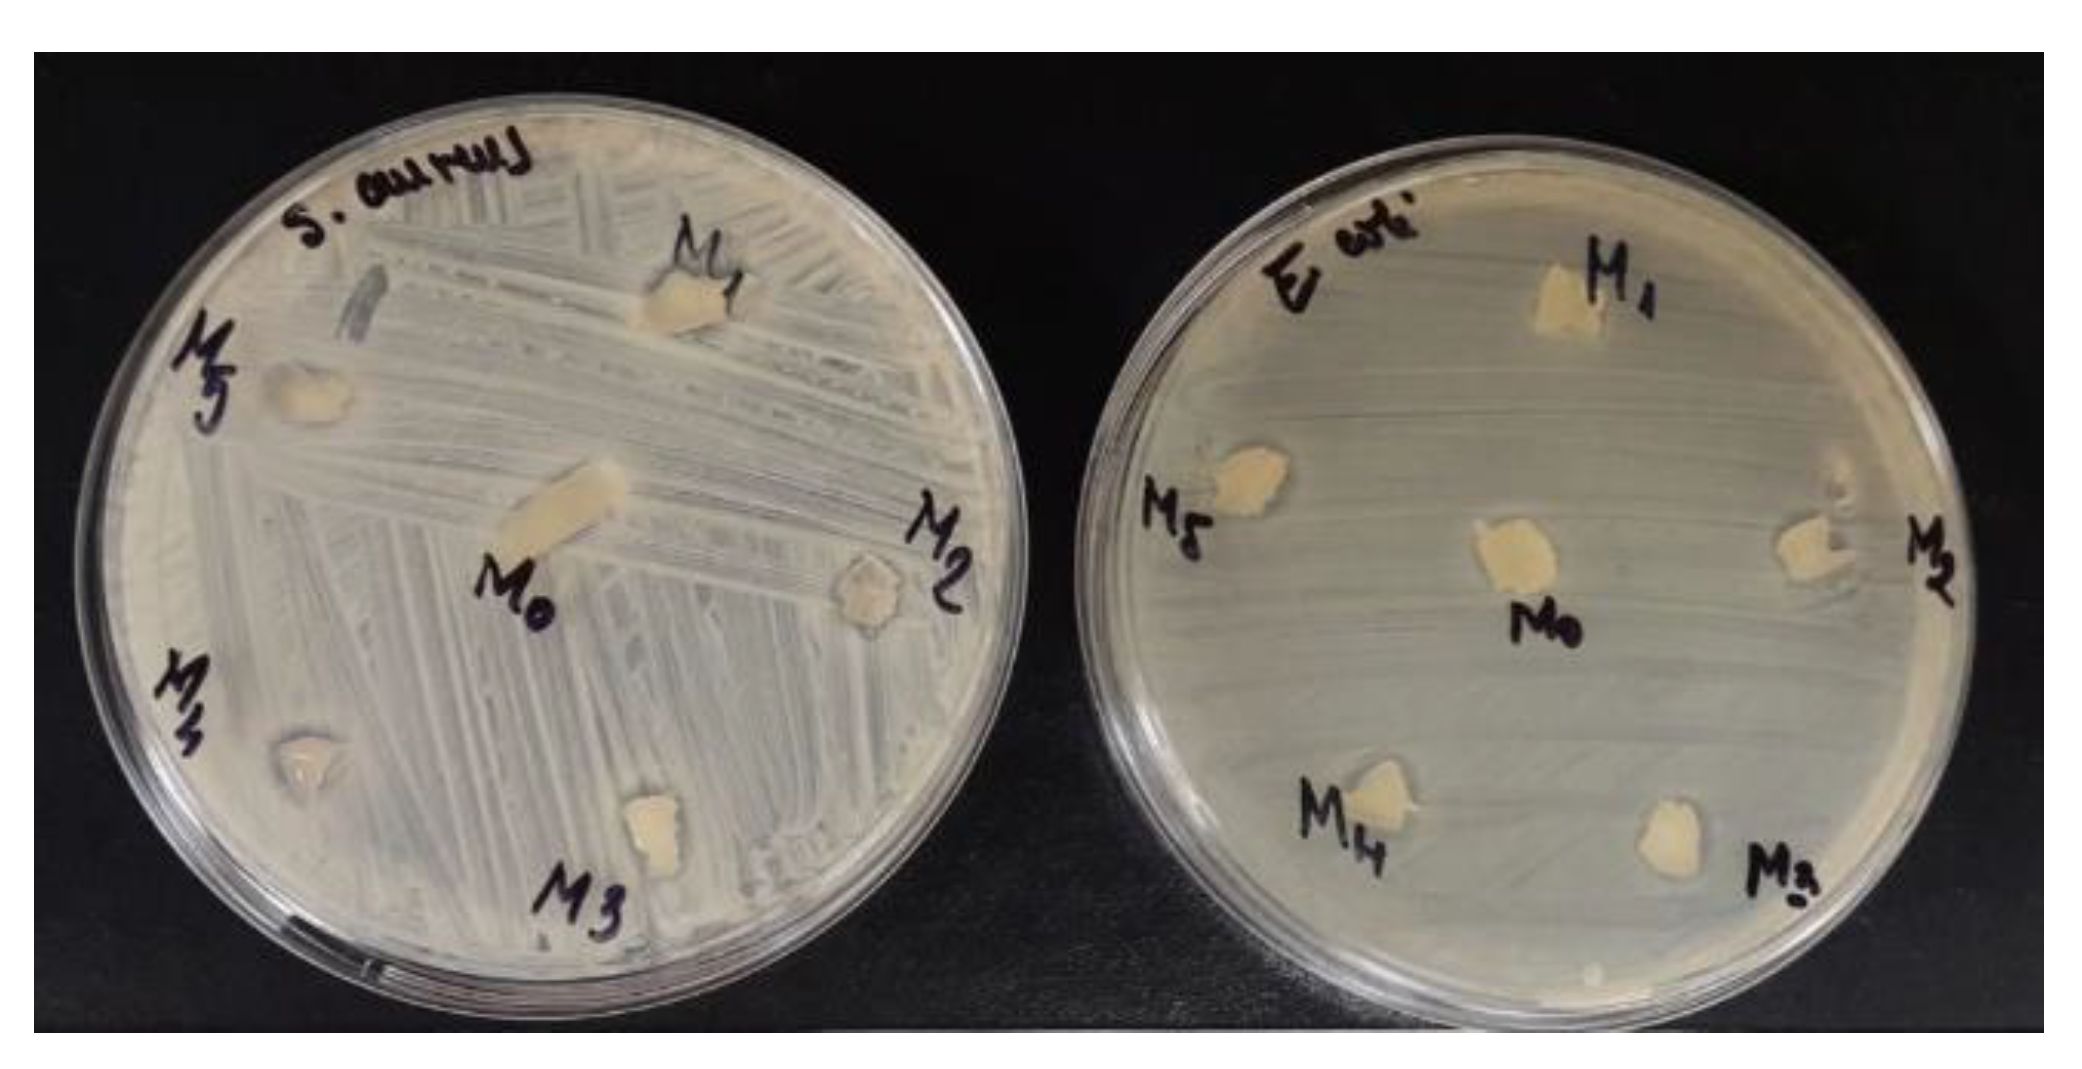
Materials 15 02657 g010
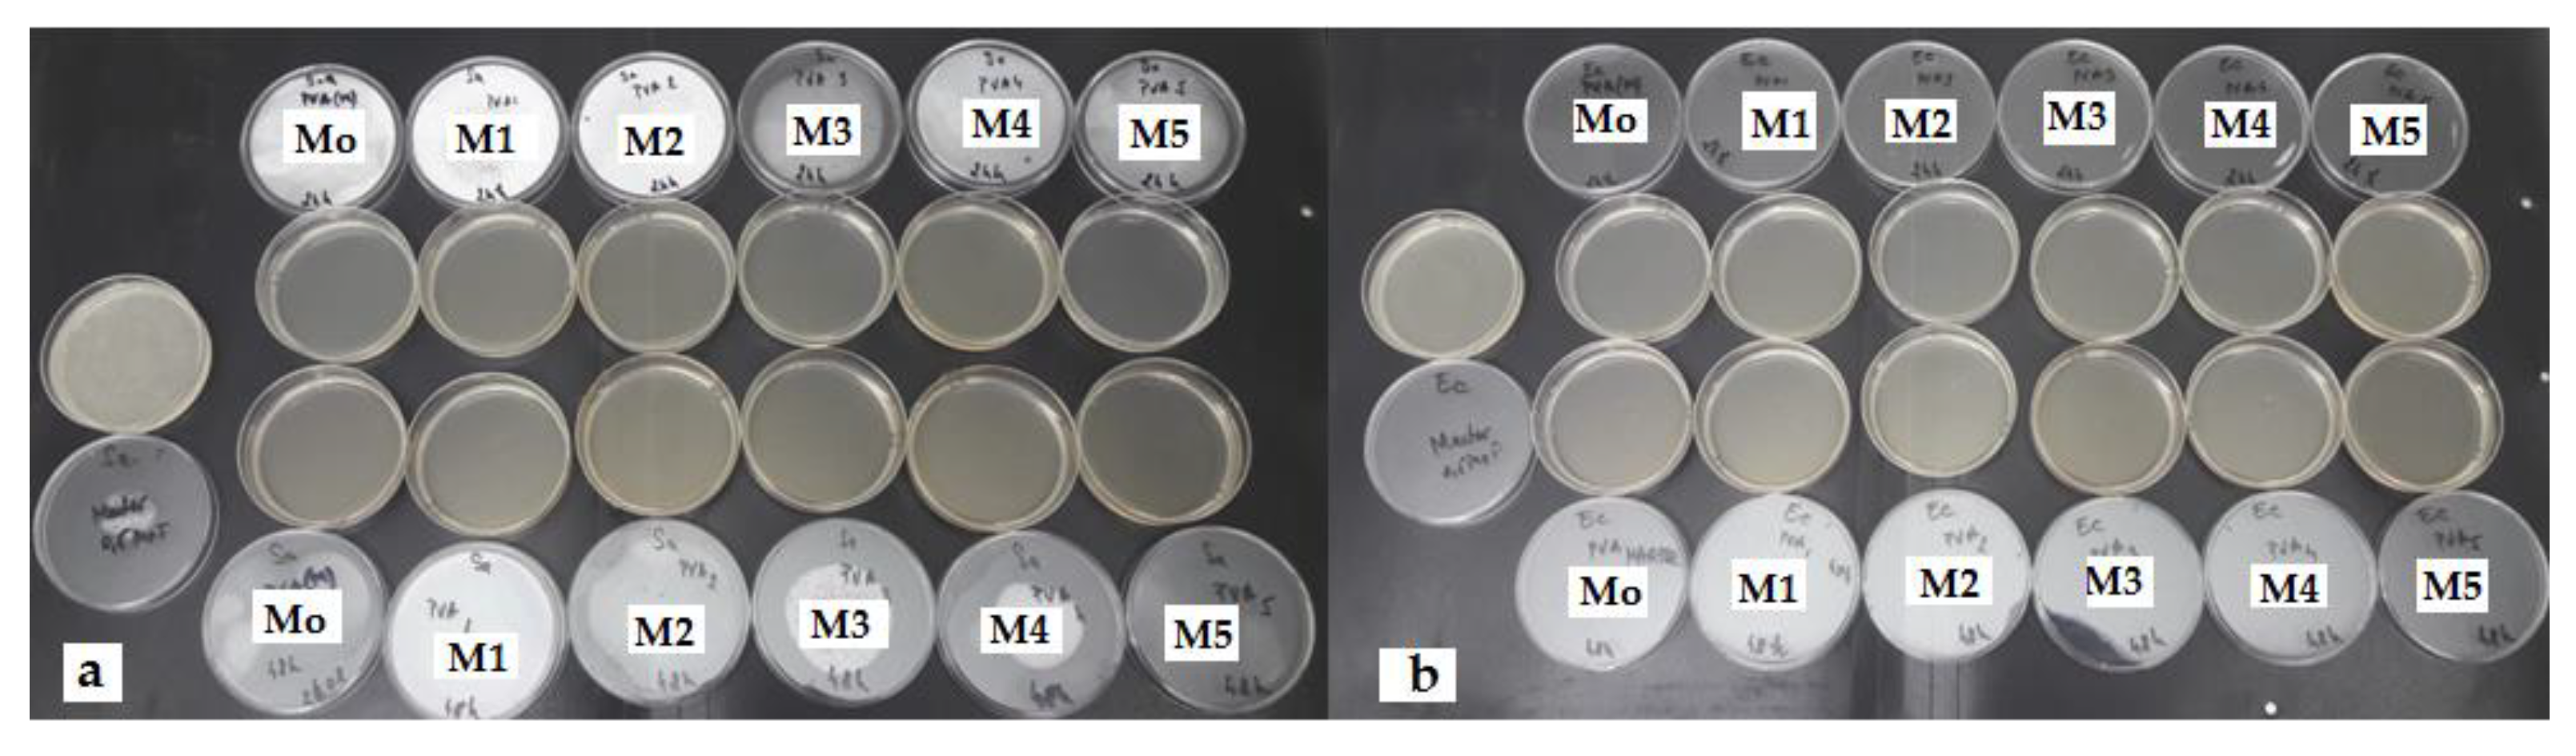
Materials 15 02657 g011

Tunable Properties via Composition Modulations of Poly(vinyl alcohol)/Xanthan Gum/Oxalic Acid Hydrogels
Abstract
:1. Introduction
2. Materials and Methods
2.1. Materials
2.2. Methods
2.3. Preparation of PVA/XG Hydrogels
3. Results and Discussions
3.1. Structural Characterization
3.2. Morphological Investigation
3.3. Porosity
3.4. Swelling Behavior and Kinetic Studies of PVA/XG Hydrogels
3.5. Mechanical Properties
3.6. Antibacterial Activity of PVA/XG Hydrogels
4. Conclusions
Author Contributions
Funding
Institutional Review Board Statement
Informed Consent Statement
Data Availability Statement
Acknowledgments
Conflicts of Interest
References
- Ullah, A.; Lim, S.I. Bioinspired tunable hydrogels: An update on methods of preparation, classification, and biomedical and therapeutic applications. Int. J. Pharm. 2022, 612, 121368. [Google Scholar] [CrossRef] [PubMed]
- Yang, Y.; Xu, L.; Wang, J.; Meng, Q.; Zhong, S.; Gao, Y.; Cui, X. Recent advances in polysaccharide-based self-healing hydrogels for biomedical applications. Carbohydr. Polym. 2022, 283, 119161. [Google Scholar] [CrossRef] [PubMed]
- Kailasa, S.K.; Joshi, D.J.; Kateshiya, M.R.; Koduru, J.R.; Malek, N.I. Review on the biomedical and sensing applications of nanomaterial-incorporated hydrogels. Mater. Today Chem. 2022, 23, 100746. [Google Scholar] [CrossRef]
- Sapalidis, A.A. Porous Polyvinyl alcohol membranes: Preparation methods and applications. Symmetry 2020, 12, 960. [Google Scholar] [CrossRef]
- Halima, N.B. Poly (vinyl alcohol): Review of its promising applications and insights into biodegradation. RSC Adv. 2016, 6, 39823–39832. [Google Scholar] [CrossRef]
- Teodorescu, M.; Bercea, M.; Morariu, S. Biomaterials of PVA and PVP in medical and pharmaceutical applications: Perspectives and challenges. Biotechnol. Adv. 2019, 37, 109–131. [Google Scholar] [CrossRef]
- Li, T.; Ibáñez-Ibáñez, P.F.; Håkonsen, V.; Wu, J.; Xu, K.; Zhuo, Y.; Luo, S.; He, J.; Zhang, Z. Self-Deicing Electrolyte Hydrogel Surfaces with Pa-level Ice Adhesion and Durable Antifreezing/Antifrost Performance. ACS Appl. Mater. Interfaces 2020, 12, 35572–35578. [Google Scholar] [CrossRef]
- Wong, C.Y.; Wong, W.Y.; Loh, K.S.; Daud, W.R.W.; Lim, K.L.; Khalid, M.; Walvekar, R. Development of poly (vinyl alcohol)-based polymers as proton exchange membranes and challenges in fuel cell application: A review. Polym. Rev. 2020, 60, 171–202. [Google Scholar] [CrossRef]
- Kamoun, E.A.; Chen, X.; Eldin, M.S.M.; Kenawy, E.-R.S. Crosslinked poly (vinyl alcohol) hydrogels for wound dressing applications: A review of remarkably blended polymers. Arab. J. Chem. 2015, 8, 1–14. [Google Scholar] [CrossRef] [Green Version]
- Mitura, S.; Sionkowska, A.; Jaiswal, A. Biopolymers for hydrogels in cosmetics: Review. J. Mater. Sci. Mater. Med. 2020, 31, 50. [Google Scholar] [CrossRef]
- Gohil, J.M.; Ray, P. Studies on Oxalic Acid as a Crosslinker of Polyvinyl Alcohol. Polym. Polym. Compos. 2009, 17, 403–410. [Google Scholar] [CrossRef]
- Adelnia, H.; Ensandoost, R.; Moonshi, S.S.; Gavgani, J.N.; Vasafi, E.I.; Ta, H.T. Freeze/thawed Polyvinyl Alcohol Hydrogels: Present, Past and Future. Eur. Polym. J. 2021, 164, 110974. [Google Scholar] [CrossRef]
- Kobayashi, M.; Hyu, H.S. Development and evaluation of polyvinyl alcohol-hydrogels as an artificial atrticular cartilage for orthopedic implants. Materials 2010, 3, 2753–2771. [Google Scholar] [CrossRef] [Green Version]
- Crosby, C.O.; Stern, B.; Kalkunte, N.; Pedahzur, S.; Ramesh, S.; Zoldan, J. Interpenetrating polymer network hydrogels as bioactive scaffolds for tissue engineering. Rev. Chem. Eng. 2022, 38, 347–361. [Google Scholar] [CrossRef]
- Vilgis, T.A. Soft matter food physics—The physics of food and cooking. Rep. Prog. Phys. Phys. Soc. 2015, 78, 124602. [Google Scholar] [CrossRef]
- Mondal, D.; Mollick, M.M.R.; Bhowmick, B.; Maity, D.; Bain, M.K.; Rana, D.; Mukhopadhyay, A.; Dana, K.; Chattopadhyay, D. Effect of poly(vinyl pyrrolidone) on the morphology and physical properties of poly(vinyl alcohol)/sodium montmorillonite nanocomposite films. Prog. Nat. Sci. Mater. Int. 2013, 23, 579–587. [Google Scholar] [CrossRef] [Green Version]
- Julinová, M.; Vaňharová, L.; Jurča, M. Water-soluble polymeric xenobiotics–Polyvinyl alcohol and polyvinylpyrrolidon–And potential solutions to environmental issues: A brief review. J. Environ. Manag. 2018, 228, 213–222. [Google Scholar] [CrossRef]
- Kang, M.; Oderinde, O.; Liu, S.; Huang, Q.; Ma, W.; Yao, F.; Fu, G. Characterization of Xanthan gum-based hydrogel with Fe3+ ions coordination and its reversible sol-gel conversion. Carbohydr. Polym. 2019, 203, 139–147. [Google Scholar] [CrossRef]
- Elella, M.H.A.; Goda, E.S.; Gab-Allah, M.A.; Hong, S.E.; Pandit, B.; Lee, S.; Gamal, H.; ur Rehman, A.; Yoon, K.R. Xanthan gum-derived materials for applications in environment and eco-friendly materials: A review. J. Environ. Chem. Eng. 2021, 9, 104702. [Google Scholar] [CrossRef]
- Zhang, Q.; Hu, X.; Wu, M.; Wang, M.; Zhao, Y.; Li, T. Synthesis and performance characterization of poly (vinyl alcohol)-xanthan gum composite hydrogel. React. Funct. Polym. 2019, 136, 34–43. [Google Scholar] [CrossRef]
- Wei, J.; Zhao, Y.; Yu, S.; Du, J.; Hu, X.; Bai, G.; Wang, Z. Environment-friendly dual-network hydrogel dust suppressant based on xanthan gum, polyvinyl alcohol and acrylic acid. J. Environ. Manag. 2021, 295, 113139. [Google Scholar] [CrossRef] [PubMed]
- Ray, S.; Banerjee, S.; Maiti, S.; Laha, B.; Barik, S.; Sa, B.; Bhattacharyya, U.K. Novel interpenetrating network microspheres of xanthan gum–poly(vinyl alcohol) for the delivery of diclofenac sodium to the intestine—In vitro and in vivo evaluation. Drug Deliv. 2010, 17, 508–519. [Google Scholar] [CrossRef] [PubMed] [Green Version]
- Leone, G.; Consumi, M.; Lamponi, S.; Bonechi, C.; Tamasi, G.; Donati, A.; Rossi, C.; Magnani, A. Hybrid PVA-xanthan gum hydrogels as nucleus pulposus substitutes. Int. J. Polym. Mater. Polym. Biomater. 2019, 68, 681–690. [Google Scholar] [CrossRef]
- Brunchi, C.-E.; Bercea, M.; Morariu, S.; Avadanei, M. Investigations on the interactions between xanthan gum and poly(vinyl alcohol) in solid state and aqueous solutions. Eur. Polym. J. 2016, 84, 161–172. [Google Scholar] [CrossRef]
- Serbezeanu, D.; Bargan, A.; Homocianu, M.; Aflori, M.; Rîmbu, C.M.; Enache, A.A.; Vlad-Bubulac, T. Electrospun Polyvinyl Alcohol Loaded with Phytotherapeutic Agents for Wound Healing Applications. Nanomaterials 2021, 11, 3336. [Google Scholar] [CrossRef] [PubMed]
- Silverstein, R.M.; Webster, F.X.; Kiemle, D.J. Identificação espectrométrica de compostos orgânicos. In Identificação Espectrométrica de Compostos Orgânicos; Livros Técnicos e Científicos: Rio de Janeiro, Brazil, 2007; p. 490. [Google Scholar]
- Coates, J. Encyclopedia of analytical chemistry. In Interpretation of Infrared Spectra, a Practical Approach; Wiley: Chichester, UK, 2000; pp. 10815–10837. [Google Scholar]
- Su, L.; Ji, W.; Lan, W.; Dong, X.Q. Chemical modification of xanthan gum to increase dissolution rate. Carbohydr. Polym. 2003, 53, 497–499. [Google Scholar] [CrossRef]
- Raschip, I.E.; Fifere, N.; Varganici, C.-D.; Dinu, M.V. Development of antioxidant and antimicrobial xanthan-based cryogels with tuned porous morphology and controlled swelling features. Int. J. Biol. Macromol. 2020, 156, 608–620. [Google Scholar] [CrossRef] [PubMed]
- Mour, M.; Das, D.; Winkler, T.; Hoenig, E.; Mielke, G.; Morlock, M.M.; Schilling, A.F.J.M. Advances in porous biomaterials for dental and orthopaedic applications. Materials 2010, 3, 2947–2974. [Google Scholar] [CrossRef] [Green Version]
- Szczepkowska, M.; Łuczuk, M. Porous materials for the medical applications. Syst. Wspomagania Inzynierii Prod. 2014, 2, 231–239. [Google Scholar]
- Paciorek, J.J.T. Materiały porowate—Własciwosci i zastosowanie. Trendy vzdel. 2012, 5, 229–232. [Google Scholar]
- Živić, F.; Grujović, N.; Mitrović, S.; Adamović, D.; Petrović, V.; Radovanović, A.; Đurić, S.; Palić, N. Friction and Adhesion in Porous Biomaterial Structure. Tribol. Ind. 2016, 38, 361–370. [Google Scholar]
- Lee, J.T.; Chow, K.L.; Wang, K.; Tsang, W.-H. Is macroporosity absolutely required for preliminary in vitro bone biomaterial study? A comparison between porous materials and flat materials. J. Funct. Biomater. 2011, 2, 308–337. [Google Scholar] [CrossRef] [Green Version]
- Porta-i-Batalla, M.; Eckstein, C.; Xifré-Pérez, E.; Formentín, P.; Ferré-Borrull, J.; Marsal, L.F. Sustained, controlled and stimuli-responsive drug release systems based on nanoporous anodic alumina with layer-by-layer polyelectrolyte. Nanoscale Res. Lett. 2016, 11, 1–9. [Google Scholar] [CrossRef] [Green Version]
- Sawant, R.M.; Hurley, J.; Salmaso, S.; Kale, A.; Tolcheva, E.; Levchenko, T.; Torchilin, V.P. “SMART” drug delivery systems: Double-targeted pH-responsive pharmaceutical nanocarriers. Bioconjugate Chem. 2006, 17, 943–949. [Google Scholar] [CrossRef] [Green Version]
- Ganji, F.; Vasheghani, F.S.; Vasheghani, F.E. Theoretical Description of Hydrogel Swelling: A Review. Iran. Polym. J. 2010, 19, 375–398. [Google Scholar]
- Bajpai, S. Swelling Studies on Hydrogel Networks—A Review. J. Sci. Ind. Res. 2001, 60, 451–462. [Google Scholar]
- Gupta, P.; Vermani, K.; Garg, S. Hydrogels: From controlled release to pH-responsive drug delivery. Drug Discov. Today 2002, 7, 569–579. [Google Scholar] [CrossRef]
- Laftah, W.A.; Hashim, S.; Ibrahim, A.N. Polymer hydrogels: A review. Polym. -Plast. Technol. Eng. 2011, 50, 1475–1486. [Google Scholar] [CrossRef]
- Schott, H. Swelling kinetics of polymers. J. Macromol. Sci. Part B 1992, 31, 1–9. [Google Scholar] [CrossRef]
- Wang, Z.; Yang, Q.; Wang, X.; Li, R.; Qiao, H.; Ma, P.; Sun, Q.; Zhang, H. Antibacterial activity of xanthan-oligosaccharide against Staphylococcus aureus via targeting biofilm and cell membrane. Int. J. Biol. Macromol. 2020, 153, 539–544. [Google Scholar] [CrossRef]
- Mirzadeh, M.; Arianejad, M.R.; Khedmat, L. Antioxidant, antiradical, and antimicrobial activities of polysaccharides obtained by microwave-assisted extraction method: A review. Carbohydr. Polym. 2020, 229, 115421. [Google Scholar] [CrossRef] [PubMed]

| Samples | PVA (g) | Xanthan Gum (g) | Oxalic Acid (g) | Distilled Water (mL)/(%) |
|---|---|---|---|---|
| PVA/XG-100/0 | 0.5 | 0 | 0.08 | 7.25/8 |
| PVA/XG-90/10 | 0.45 | 0.05 | 0.08 | 7.25/8 |
| PVA/XG-80/20 | 0.4 | 0.1 | 0.08 | 7.25/8 |
| PVA/XG-70/30 | 0.35 | 0.15 | 0.08 | 7.25/8 |
| PVA/XG-60/40 | 0.3 | 0.2 | 0.08 | 7.25/8 |
| PVA/XG-50/50 | 0.25 | 0.25 | 0.08 | 7.25/8 |
| Samples | Porosity (%) | Average Pore Diameters (mm) | Seq a (%) | Schott’s Second Order Kinetics | ||
|---|---|---|---|---|---|---|
| S∞ b (g/g) | Ksc (g/min *g) | R2d | ||||
| PVA/XG-100/0 | 70 | 0.028 ± 0.007 | 1105.17 ± 55.25 | 10.81 | 0.02 | 0.9998 |
| PVA/XG-90/10 | 69 | 0.029 ± 0.017 | 1242.44 ± 62.12 | 12.43 | 0.07 | 0.9999 |
| PVA/XG-80/20 | 70 | 0.030 ± 0.009 | 1308.10 ± 65.40 | 13.05 | 0.1 | 0.9999 |
| PVA/XG-70/30 | 70 | 0.040 ± 0.015 | 1421.28 ± 71.06 | 14.12 | 0.09 | 0.9999 |
| PVA/XG-60/40 | 67 | 0.060 ± 0.011 | 1354.16 ± 67.70 | 13.53 | 0.04 | 0.9999 |
| PVA/XG-50/50 | 86 | 0.064 ± 0.024 | 1390.50 ± 64.52 | 13.90 | 0.11 | 0.9999 |
| Samples | Weight (g) | Staphylococcus aureus ATCC 25923 | Escherichia coli ATCC 25922 | ||||||
|---|---|---|---|---|---|---|---|---|---|
| DM | CTM | DM | CTM | ||||||
| M(+) CFU/mL | 24 h CFU/mL | 48 h CFU/mL | M(+) CFU/mL | 24 h CFU/mL | 48 h CFU/mL | ||||
| PVA/XG-100/0 | 0.05 | + | 1.5 × 108 | 0 | 0 | + | 1.5 × 108 | 0 | 0 |
| PVA/XG-90/10 | 0.05 | + | 1.5 × 108 | 0 | 0 | + | 1.5 × 108 | 0 | 0 |
| PVA/XG-80/20 | 0.05 | + | 1.5 × 108 | 0 | 0 | + | 1.5 × 108 | 0 | 0 |
| PVA/XG-70/30 | 0.05 | + | 1.5 × 108 | 0 | 0 | + | 1.5 × 108 | 0 | 0 |
| PVA/XG-60/40 | 0.05 | + | 1.5 × 108 | 0 | 0 | + | 1.5 × 108 | 0 | 0 |
| PVA/XG-50/50 | 0.05 | + | 1.5 × 108 | 0 | 0 | + | 1.5 × 108 | 0 | 0 |
Publisher’s Note: MDPI stays neutral with regard to jurisdictional claims in published maps and institutional affiliations. |
© 2022 by the authors. Licensee MDPI, Basel, Switzerland. This article is an open access article distributed under the terms and conditions of the Creative Commons Attribution (CC BY) license (https://creativecommons.org/licenses/by/4.0/).
Share and Cite
Enache, A.A.; Serbezeanu, D.; Vlad-Bubulac, T.; Ipate, A.-M.; Suflet, D.M.; Drobotă, M.; Barbălată-Mândru, M.; Udrea, R.M.; Rîmbu, C.M. Tunable Properties via Composition Modulations of Poly(vinyl alcohol)/Xanthan Gum/Oxalic Acid Hydrogels. Materials 2022, 15, 2657. https://doi.org/10.3390/ma15072657
Enache AA, Serbezeanu D, Vlad-Bubulac T, Ipate A-M, Suflet DM, Drobotă M, Barbălată-Mândru M, Udrea RM, Rîmbu CM. Tunable Properties via Composition Modulations of Poly(vinyl alcohol)/Xanthan Gum/Oxalic Acid Hydrogels. Materials. 2022; 15(7):2657. https://doi.org/10.3390/ma15072657
Chicago/Turabian StyleEnache, Alin Alexandru, Diana Serbezeanu, Tăchiță Vlad-Bubulac, Alina-Mirela Ipate, Dana Mihaela Suflet, Mioara Drobotă, Mihaela Barbălată-Mândru, Radu Mihail Udrea, and Cristina Mihaela Rîmbu. 2022. "Tunable Properties via Composition Modulations of Poly(vinyl alcohol)/Xanthan Gum/Oxalic Acid Hydrogels" Materials 15, no. 7: 2657. https://doi.org/10.3390/ma15072657
APA StyleEnache, A. A., Serbezeanu, D., Vlad-Bubulac, T., Ipate, A.-M., Suflet, D. M., Drobotă, M., Barbălată-Mândru, M., Udrea, R. M., & Rîmbu, C. M. (2022). Tunable Properties via Composition Modulations of Poly(vinyl alcohol)/Xanthan Gum/Oxalic Acid Hydrogels. Materials, 15(7), 2657. https://doi.org/10.3390/ma15072657

